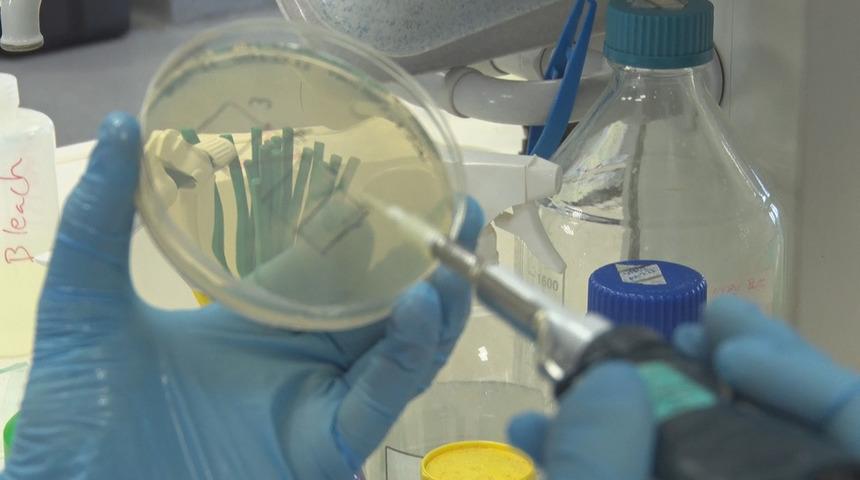
'Koronavir&uuml;s biyolojik silah mı?' sorusuna T&uuml;rk uzmandan yanıt

Virüsleri kullanarak vücuttaki “Natural Killer” yani “doğal öldürücü hücrelerin” genetiğini değiştirip sadece kanser hücrelerine saldıracak hale getiren, bu yolla da tümörlerin bağışıklık sisteminin kendisi tarafından yok edilmesini hedefleyen Boğaziçi Üniversitesi Moleküler Biyoloji ve Genetik Bölümü Öğretim Üyesi Dr. Tolga Sütlü, bu şekilde pek çok kanser türüne karşı tedavi geliştirmeyi amaçlıyor. “Kanser immünoterapisi” alanında yürüttüğü çalışmaları TÜBİTAK tarafından da desteklenen Dr. Tolga Sütlü, çalışmalarında virüsleri ‘bir araç olarak’ sıkça kullanıyor. Dr. Sütlü, son günlerde dünyanın gündeminden düşmeyen yeni tip koronavirüs “Covid-19” ile ilgili de şu uyarılarda bulundu:
"Bu yeni koronavirüs’ün bu kadar hızlı yayılmasının sebeplerinden biri, henüz semptom bile başlamadan, yani kuluçka döneminde dahi buluşabilme özelliği. Virüsler, ancak konaklar (insan, hayvan vb) üzerinde kendilerini değiştirebildikleri için ne kadar çok yayılırsa o kadar hızlı ve fazla mutasyon geçirir. Bu da virüsün yeni özellikleriyle, belki daha da güçlenerek karşımıza çıkması demektir. Şu anda tüm dünyadaki sıkı karantina önlemlerinin en büyük nedeni bu yayılımın kısıtlanmasıdır. Virüs çok ölümcül olduğu için değil yani. Covid-19 bir biyolojik silah değil. Buna dair hiçbir bilimsel kanıt yok. Bir virüsün gen dizisini analiz etmek mümkün. ‘İnsan eliyle’ bir genetik değişiklik yapılmış mı anlaşılır. Teknik bilgisi olan birinin fotomontajlı bir resimdeki değişikliği tespit edebilmesi gibi. Çin’e karşı biyolojik saldırı olsaydı Çin bunu iki günde tespit edip gösterebilirdi.”

‘KATİL’ HÜCRELER KANSERİ TEDAVİ EDECEK
Kanser tedavisi için araştırmalar yürüten Dr. Tolga Sütlü, bağışıklık sistemindeki doğal öldürücü hücrelerin farklı kanserlerdeki tedavi edici etkilerini ortaya çıkarmaya çalıştıklarını anlatarak, “En son melanom ve sarkoma’daki çalışmalarımız yayınlandı ama asıl amacımız pek çok kanser türüne uygulanabilecek bir tedavi geliştirmek. Farklı farklı kanser türleri üzerinde çalışıyoruz bu nedenle. Kanser zaten aslında vücudumuzun içinde yabancılaşmış bir yapı. Bağışıklık sistemi normalde vücuttaki yabancı her yapıyı anında fark edip ona saldırır. Vücudumuzda her gün mikroskobik düzeyde birçok tümör gelişir ve bağışıklık sistemimiz bunu temizler. Ama kansere yakalanan bireylerde bu mekanizma başarıyla çalışmıyor ve kanser hücreleri baskın hale gelip vücudu ele geçirmeye çalışıyor. İşte biz, bağışıklık sistemini kansere karşı tekrar nasıl harekete geçirebiliriz ve tümörü ortadan kaldırmasını sağlayabiliriz, bunun için farklı ve yeni tedavi yöntemleri geliştirmeye uğraşıyoruz. Bunun için de virüsleri kullanıyoruz” dedi.
‘BAĞIŞIKLIK HÜCRELERİNİ VİRÜSLERLE MODİFİYE EDİYORUZ’
Dr. Sütlü, bağışıklık sisteminin tümör hücrelerini sağlıklı hücrelerden ayırt edebilmesi ve doğal öldürücü hücrelerin harekete geçerek tümöre saldırması için, onlara bazı özellikler kazandırmaya çalıştıklarını söyleyerek şöyle açıkladı:
“Bunu da hücreyi genetik olarak değiştirerek yapabiliyoruz. Ama bu değişimi hücreye direkt müdahale ile yapmak mümkün değil. Virüsler burada bizim için araç oluyor. Virüsler normalde dışarıdan hücre içine girer ve burada kendilerini çoğaltarak hızla tüm hücrelere yayılabilir. Biz, laboratuvar ortamında hastalık yapıcı tüm özelliklerini yok edip güvenli hale getirdiğimiz virüsleri genetiğini de değiştirerek, DNA parçası ekliyoruz ve virüs vasıtasıyla hücreye bu DNA’yı sokmuş oluyoruz. Böylece hücreye istediğimiz özelliği kazandırmış oluyoruz. Başka yöntemler de var, örneğin nanoparçacıklar ile bunu yapmaya çalışan bazı yaklaşımlar var. Ama daha verimli ve daha hızlı yapabilmek için virüsleri kullanıyoruz.”

BAĞIŞIKLIK HAFIZASINA ALINAN HASTALIK NÜKSETMEYECEK
Cilt kanseri olan melanom’da bu şekilde yaptıkları çalışmada, tümör hücreleri üzerinde bulunan spesifik bir tümör molekülünü tanıyacak “doğal öldürücü hücreler” geliştirmeyi başardıklarını anlatan Dr. Sütlü sözlerini şöyle tamamladı:
“Bunların da tümörü öldürmekte çok daha verimli ve başarılı olduğunu gördük. Bunu hem laboratuvar ortamında, hem de hayvan deneylerinde, fareler üzerinde gösterdik. TÜBİTAK tarafından desteklenen bu projemizde şimdi, Uludağ Üniversitesi’yle de yaptığmız işbirliği ile önümüzdeki 3-4 yıl boyunca melanom hastalarından alınan örnekleri toplayacağız ve laboratuvar ortamında bu örnekler üzerinde bu tedavi yöntemi verimli bir şekilde çalışıyor mu, bunu analiz edeceğiz. Sonuçlarımız olumlu çıkarsa, 5 yıl içinde hasta denemelerine geçeceğiz. Uzun vadede de hastalar üzerinde uygulanabileceğini düşündüğümüz bir tedavi geliştirmek yolunda ilerliyoruz. İmmünoterapi olarak özetleyebileceğimiz bu tedavinin en büyük avantajı, hedefli tedaviler olması. Bir diğer avantajı da özellikle bağışıklık sistemini kullanarak geliştirdiğimiz tedavilerde vücudun bunu hatırlaması. Yani mesela bir enfeksiyon geçirdiğinizde ya da aşı olduğunuzda vücudunuz ileride bu etkeni hatırlar ve hastalık tekrarlasa bile vücut onunla savaşmayı öğrendiği için, çok daha kolay atlatırsınız. Hemen hemen her kanserde relaps yani nüks çok sık yaşanan bir durum. Örneğin ilik kanseri ya da miyelom hastalarının yüzde 99’unda hastalık geri gelir. Kanserde immünoterapi ile işte bu bağışıklık sisteminin hafıza özelliği sayesinde, hastalığın nüksetmesinin önüne geçilebilecek. Çünkü bağışıklık sistemi, mikroskobik düzeyde kalmış son birkaç hücreyi dahi tarayarak bulup yok edebilecek.”
Kaynak: DHA